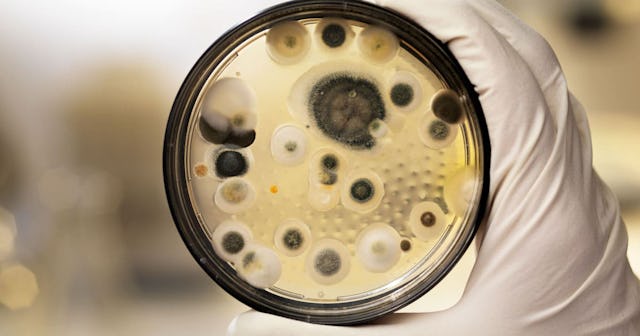

Seattle Children's Hospital Closes 10 Operating Rooms After Mold Killed 6 Patients
At least 14 people became sick with mold infections, and 6 have died
Seattle Children’s Hospital has shut down 10 of its operating rooms to install new air filtration systems after the deaths of six patients were linked to mold infestations that have apparently been ongoing at the hospital for nearly two decades.
“We have been working to make our operating rooms safe to prevent aspergillus infections,” the hospital’s CEO Jeff Sperring said at a news conference earlier this week. “To date, we have not been successful.”
Aspergillus is a type of mold so common, healthy people breathe it every day with no ill effects, but when it enters a surgical wound, it can cause a dangerous infection with symptoms like heat at the infection site and swelling. In severe cases, patients can develop a fungal infection in their lungs after breathing in spores. People with compromised immune systems or lung diseases are particularly at risk. News reports say that since 2001, at least 14 people at Seattle Children’s have become sick with infections from aspergillus at surgical sites.
“At the time, we believed those were isolated incidents,” Sperring said at the news conference. “We now believe that these infections were likely caused by the air-handling system that serves our operating rooms.”
He continued, “Looking back, we should have made the connection sooner. Simply put, we failed.”
They definitely failed, because all the information was there. State and county health department records show there have been mold problems at Seattle Children’s for years. Just last year, one surgeon reported that debris fell out of an air diffuser into a patient’s open abdomen during a surgery.
The custom air filtration the hospital is now installing includes HEPA air filtration systems, which Sperring said are “the highest level of filtration found in operating rooms today.” They remove 99.97 percent of all particles in the air that moves through the filter. Operating rooms will be closed during the upgrades, which are estimated to be finished by the end of January. Until then, surgeries scheduled at Seattle Children’s will be moved to other hospitals.
“We know this closure will result in the postponement of many surgeries, and we are sorry for the impact this will have on our patients and families,” a statement from the hospital reads. “We are confident this is the safest option for our patients.”
In his speech, Sperring apologized to the people who became sick, their families, and everyone who will be affected by the operating rooms being closed for several months.
“This is simply devastating for them and for us,” he said. “You are extraordinary kids, courageous families. We let you down and I am sorry.”